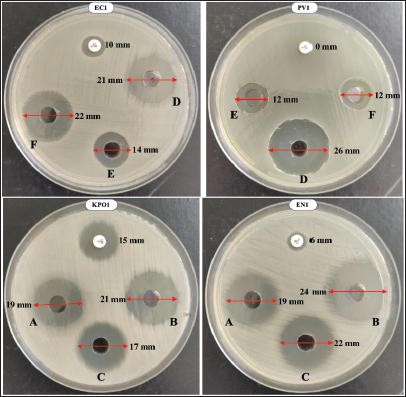

| Research Article | ||
Open Vet. J.. 2026; 16(2): 877-906 Open Veterinary Journal, (2026), Vol. 16(2): 877-906 Research Article Ethnopharmacological knowledge and antibacterial activity of camel urine in southern Morocco: Influence of physiological, nutritional, and ecological factorsAmina Ressmi1*, Habiba Raqraq1, Asmaa Dihmane1, Rafik Aniba1, Yosra Hadj Mansour3,4, Nabila Soraa2 and Abouddihaj Barguigua11Team of Biotechnology and Sustainable Development of Natural Resources, Biology Geology Department, Polydisciplinary Faculty, Sultan Moulay Slimane University, Beni Mellal, Morocco 2Laboratory of Microbiology, University Hospital Mohamed VI, Faculty of Medicine and Pharmacy, Cadi Ayyad University, Marrakech, Morocco 3LR16ES19 Laboratory for Environmental Engineering and Eco-Technology (GEET), National Engineering School of Sfax, University of Sfax, Sfax, Tunisia 4LR22ES01 Laboratory of Biomathematics, Faculty of Sciences of Sfax, Department of Mathematics, Sfax, Tunisia *Corresponding Author: Amina Ressmi. Team of Biotechnology and Sustainable Development of Natural Resources, Biology Geology Department, Polydisciplinary Faculty, Sultan Moulay Slimane University, Beni Mellal, Morocco. Email: amina.ressmi [at] usms.ac.ma Submitted: 08/10/2025 Revised: 15/01/2026 Accepted: 30/01/2026 Published: 28/02/2026 © 2026 Open Veterinary Journal
AbstractBackground: Camel urine (CU) has been used in traditional medicine across North Africa and the Middle East to treat various diseases and infections. Bacteria-induced illnesses remain a critical threat to human health worldwide. Aim: In this context, the present study aimed to bridge ethnopharmacological knowledge with laboratory evidence by documenting traditional beliefs regarding CU and evaluating its in vitro antibacterial efficacy against both standard and multidrug-resistant (MDR) bacteria. Methods: Semi-structured interviews with 450 informants to record their use of CU and perceptions of factors believed to enhance its medicinal effectiveness. The key variables of interest included storage, season, age, breed, physiological status, and camel dietary regimen. In parallel, 62 urine samples were collected based on these traditional criteria and tested in vitro against bacteria using the agar well diffusion method. Microscopical and biochemical parameters, along with Fourier transform infrared spectroscopy, were all performed to investigate factors influencing the antibacterial activity of CU. Results: CU is traditionally used against viral (52%), bacterial (30%), and fungal (8%) infections. Most participants favored urine from pregnant camels (86.11%), especially during the first trimester (40%), and from those grazing on desert plants in the wet season (99.44%), whereas breed (68.89%) and age (76.67%) were considered unimportant. In vitro tests confirmed broad-spectrum antibacterial activity in all 62 samples, with no significant seasonal effect (p=0.218), but urine from early pregnancy showed stronger activity for both American type culture collection and MDR strains. Biochemical profiling of the most active samples revealed lower sodium and salinity, higher pH, and elevated levels of chloride, potassium, proteins, urea, and creatinine. Fourier-transform infrared analysis identified a unique 1388 cm⁻¹ peak in the most active samples, suggesting the presence of a distinctive bioactive compound. Conclusion: These results confirm traditional therapeutic practices and suggest the potential of CU for novel antimicrobial drug development. This study emphasized the integration of community-based medicinal wisdom with experimental validation to identify effective natural treatments against contemporary health threats. Keywords: Ethnomedicinal knowledge, Camel urine, Antibacterial activity, MDR bacteria. IntroductionInfectious diseases continue to represent one of the foremost threats to global health, despite substantial advances in modern medicine. This burden has been drastically exacerbated by the alarming rise of antimicrobial resistance, which compromises the efficacy of existing antibiotics and complicates the management of even common infections. Recent global estimates attribute approximately 1.27 million deaths in 2019 to drug-resistant bacterial infections, with an overall contribution of 4.95 million deaths (WHO, 2023). Without coordinated action, this so-called “silent pandemic” is projected to intensify, potentially resulting in up to 10 million deaths per year by 2050, surpassing the mortality burden of cancer (Amsterdam, 2024). Clinically, patients suffering from resistant infections often require extended hospitalization, incur higher treatment costs, and face an increased risk of complications and mortality. The search for novel antimicrobial agents has become a global research priority in response to this growing crisis. While synthetic antibiotic pipelines struggle to keep pace, natural products and traditional medical systems are being revisited as vital sources of bioactive molecules. Ethnopharmacology at the intersection of cultural knowledge and biomedical validation has emerged as a particularly fruitful approach in this endeavor. Researchers aim to uncover compounds with genuine therapeutic potential by exploring plant- or animal-based remedies historically used to treat infections, especially in contexts where conventional health care is limited. Among the many traditional remedies under renewed scientific scrutiny, camel urine (CU) is a culturally significant and widely employed therapeutic agent (Williams, 1994; Christy, 1996). The practice of employing CU appears in medieval medical literature, including Avicienna’s 11th century text “The canon of Medicine,” which served as a cornerstone of medical knowledge for centuries (Alhaider et al., 2011). Camel-derived products such as milk, meat, and urine have long held medicinal value throughout various arid and semi-arid regions of North Africa and the Middle East (Mukasa-Mugerwa and E, 1981; Abdel Gader and Alhaider, 2016; Faye et al., 2025). In southern Morocco, local communities use CU to manage conditions such as fever, digestive disturbances, skin infections, parasitic diseases, and general weakness (Tharwat et al., 2023; Ressmi et al., 2024d). Historically, ethnographic reports have indicated its use for supporting general well-being and treating tuberculosis, anemia, leprosy, and abdominal tumors (Al-Abdalall, 2010). In some areas, CU has been taken orally when mixed with milk for gastrointestinal complaints (O’hag and Mohamedani, 2000) and has been mentioned in relation to the topical management of localized infections, ringworm, and burn injuries (Bass and Williams, 1988). It has been applied cosmetically as a traditional hair-wash preparation in some regions of the Arabian Peninsula (Abdalla et al., 2018). Despite the widespread and persistent use of CU in traditional healing systems, the scientific evaluation of its therapeutic properties remains limited. Preliminary in vitro studies have provided early evidence supporting the antibacterial, antifungal, antidiabetic, gastroprotective, hepatoprotective, and even anticancer activities of CU (Mustapha et al., 2021; Salamt et al., 2021). These findings suggest the presence of diverse bioactive compounds, including peptides, proteins, and metabolites, capable of exerting biological effects. However, CU is not a chemically uniform fluid: its composition is likely to vary based on several physiological, dietary, ecological, and genetic factors. Despite its promise, most studies to date have treated CU as a static substance, rarely considering how its efficacy may be shaped by variables such as the camel’s age, reproductive status, breed, nutritional intake, or environmental conditions. Moreover, the storage methods and treatment processes commonly used in traditional practice may further influence the pharmacological activity of the drug. A critical limitation in previous studies on the antibacterial effects of CU is the lack of characterization of the samples used, with most reports failing to specify key variables such as the animal’s sex, reproductive status, age, feeding regime, season of collection, or ecological conditions (Sumia et al., 2016; Elbehiry et al., 2021). Our ethnopharmacological survey demonstrates that such factors are not trivial: local informants do not use CU indiscriminately but deliberately obtain it from specific camels under well-defined conditions. These culturally embedded selection criteria suggest that bioactivity is context-dependent and may be influenced by physiological state, diet, and environmental adaptation. Together, these factors leave a critical knowledge gap that limits reproducibility, independent verification, and the development of reliable future applications. This limited understanding significantly constrains efforts to validate the therapeutic value of CU or to harness its constituents for biomedical applications. Thus, a more nuanced and multidimensional investigation is needed to determine not only whether CU possesses antibacterial properties but also under what specific conditions these effects are enhanced or diminished. However, previous studies that examined the antibacterial, anticancer, or antifungal properties of CU generally treated it as a uniform biological fluid, without accounting for ethnopharmacological determinants such as pregnancy stage, age, feeding regimen, season, or breed. To date, no investigation has simultaneously integrated traditional community-based criteria with systematic biochemical profiling and standardized antibacterial testing. This multidimensional gap limits both the reproducibility and mechanistic interpretation of the existing literature, thereby providing the scientific rationale and necessity for this integrative study. In this study, we present a comprehensive ethnopharmacological and laboratory-based investigation of Camelus dromedarius CU collected in southern Morocco. Focusing on the three dominant regional breeds: Marmouri, Khouari, and Guerzni, we examined the antibacterial activity of CU against both American type culture collection (ATCC) and multidrug-resistant (MDR) bacterial strains. We also performed detailed biochemical and microscopic characterizations, considering animal-related factors (age, pregnancy status, diet), environmental influences (seasonality), and practical considerations (treatment and storage methods). Through this integrative approach, we aim not only to validate long-standing ethnomedical knowledge but also to identify variables that optimize CU’s therapeutic potential. Our findings may contribute to the discovery of natural antimicrobial agents and reinforce the relevance of traditional remedies in addressing contemporary challenges in infectious disease management. Materials and MethodsStudy area and designThe survey was conducted in eight provinces in two regions (Laayoune Sakia El Hamra and Guelmim Oued Noun) in Morocco, which spans an area of 186.126 km2. They are bordered on the north by the Souss-Massa region, to the east by the Moroccan-Algerian borders, to the south by the Dakhla-Oued Edahab region and the Mauritanian borders, and to the west by the Atlantic Ocean (Fig. 1). In 2024, these provinces included approximately 899,713 inhabitants in 2024, among 36,828,330 inhabitants of the whole country (HCP Morocco, 2024). In terms of temperature records, we identified a tropical climate that is composed of two main seasons, including the wet season (winter), which spans from November to March and is characterized by maximum and minimum average temperatures below 25°C and 15°C, respectively. The dry season (summer) extends from April to October, with a daily average temperature exceeding 20°C.
Fig. 1. Site location map of the investigation area. A sequential exploratory design was adopted, beginning with field-based ethnopharmacological documentation followed by laboratory-based experimental validation. The initial phase aimed to collect indigenous knowledge regarding the medicinal use of CU for infectious diseases. Based on the outcomes of this phase, a second component focused on the in vitro evaluation of selected CU samples to investigate their antibacterial potential. The study design emphasized the close integration of traditional ecological knowledge and modern scientific techniques. The biological samples analyzed in the laboratory were selected strategically to reflect the diversity of traditional practices, without duplicating information already described in the sampling or analytical methods sections. This design enabled a culturally informed and scientifically grounded exploration of CU as a traditional therapeutic resource. Acquisition of ethnopharmacological knowledgeFigure 2 shows a schematic workflow summarizing the ethnopharmacological data collection process, camel selection criteria, urine collection procedures, and the subsequent microscopic and biochemical analyses.
Fig. 2. Workflow summarizing ethnopharmacological data collection, camel selection criteria, urine sampling, and analytical procedures. Fieldwork and participant interviewsPrior to initiating ethnopharmacological data collection, the study objectives were explained to all interviewees, and only those who gave their consent were considered to ensure the preservation of their knowledge for future generations, with full respect for their confidentiality, anonymity, and informed consent. To gather data on CU used for treating infectious diseases, an ethnopharmacological study was conducted from July 2023 to December 2023. This survey encompassed 450 respondents from all eight provinces within the study area. This required sample size was estimated using Epi-Info®, with a 95% confidence level and a 5% margin of error. Semi-structured interviews were conducted with local informants (373), camel attendants (31), and traditional practitioners (46). Questionnaire surveyA pilot study was conducted before the main survey to evaluate the questionnaire’s clarity, relevance, and structure. A small sample of 98 individuals, representative of the target population, participated in this preliminary phase. The pilot aimed to ensure that the questions were understandable and culturally appropriate, particularly those involving medical terminology such as "bacterial," "viral," and "fungal" infections. Feedback obtained during the pilot led to minor modifications in question phrasing, sequencing, and readability. This step was essential in refining the questionnaire and improving its validity and reliability for use in the broader ethnomedical survey. Cronbach’s alpha was used to assess internal consistency for selected questionnaire domains, with a resulting value of 0.891, signifying acceptable scale reliability. In comfortable public settings, informants were interviewed orally depending on their literacy level in the Hassani dialect or Arabic, ensuring they could express themselves without pressure or time limits. Each interview, which lasted between 30 and 60 minutes, was conducted only once. A mix of closed and open-ended questions was used in the survey to allow for greater depth and flexibility in responses. Information spontaneity was encouraged through informal meetings involving open discussion. Individual interviews were conducted thereafter, and data were meticulously recorded. A 40-question survey divided into five sections was designed for the final phase of the study. The structured questionnaire was composed of sociodemographic characteristics (gender, age, marital status, academic background, and earnings) and participants’ knowledge and practices regarding the use of CU (type of infectious diseases, ethnomedicinal efficacy, and source of knowledge). The third part was represented by camel-specific factors (sex, age, genetic lineage, physiological status, pasture zone, seasonal phase, and dietary sources) that may influence urine properties. The fourth section was expressed through the attributes of CU (urine pigmentation, storage conditions, administration and usage mode, time, and therapy duration). The final section focused on any unintended effects experienced or reported. A uniform questionnaire was employed for all informant groups to generate responses that could be reliably compared across groups. Data analysisThe analysis of data was supported by the calculation of several quantitative indices: informant consensus factor (ICF), relative frequency of citation (RFC), fidelity level (FL), cultural importance index (CI), informant agreement ratio (IAR). These indices were analyzed and performed using Microsoft Excel 2020 (Microsoft Corp., Seattle, WA, USA) to highlight their relevance. ICFTo assess the degree of agreement among participants regardingon the medicinal application of CU for particular illnesses. The following equation was used to calculate the index for each type of CU: ICF=(Nur − Nt) / (Nur − 1), where Nur corresponds to the cumulative number of use-reports for a particular disease category, and Nt indicates the number of different categories mentioned by respondents for that ailment (Heinrich et al., 1999). RFCTo quantify the perceived importance of each urine category, the RFC was calculated as RFC=FC/N, where FC is the number of citations per urine category and N is the total number of informants (Tardío and Pardo-de-Santayana, 2008). FLThe FL was calculated to identify the urine type most commonly used by interviewees for treating particular ailments using the following formula: FL (%)=(Np/N) x 100, where Np is the number of individuals indicating the use of a specific urine type for a given disease, while N corresponds to the total number of informants who mentioned the use of CU for any therapeutic purpose (Hassan, 2017). CIThe CI was determined by dividing the total number of use reports recorded for each urine category by the total number of informants (N) in the study area (Tardío and Pardo-de-Santayana, 2008). IARTo evaluate the level of agreement among respondents concerning urine categories, the IAR was employed, based on the formula introduced by (Trotter and Logan, 2019), as outlined below: IAR=(Nr−Na)/(Nr−1) where Nr represents the total number of use-reports recorded for the urine categories, and Na denotes the number of distinct diseases treated using these categories (Trotter and Logan, 2019). Characteristics of selected camelsThe study involved three indigenous camel (C. dromedarius) breeds native to the southern regions of Morocco: Khouari, Marmouri, and Guerzni. Each breed is locally recognized for distinct phenotypic and ecological traits. The Khouari camels are typically associated with mountainous or rocky steppe terrains. They are medium to large in size and are known for their physical robustness and adaptability to varied diets, including shrub-based grazing. This breed is often favored for transportation and meat production in the Atlas foothills. Marmouri camels are adapted to arid Saharan conditions and are commonly found on desert fringes. They have a lighter frame, high tolerance for heat and water scarcity, and are often bred for endurance and long-distance mobility. Their urine is traditionally considered more “potent” for medicinal uses by local healers. Guerzni camels are typically reared in semi-arid zones and are valued for their calm temperament and milk productivity. They often graze on diverse halophytic and xerophytic vegetation, which is believed to influence the urine biochemical composition. Guerzni camels are frequently preferred for milk and cultural ceremonies in rural communities. Inclusion criteriaAll animals included in the study (56 females and 6 males) were clinically healthy and not subjected to any form of stress at the time of sampling knowing that stress-inducing factors can significantly influence the biochemical composition of urine. The camels belonged to different age categories (<3 years; from 3 to 10 years; >10 years), and the females were classified into two distinct physiological status (28 virgin and 28 pregnant). The dromedaries grazed freely in the desert, under an extensive farming system typical of the region, feeding primarily on a variety of native shrubs and spiny plants, which constitute their natural diet. The diversity and distribution of desert plant species are strongly influenced by seasonal fluctuations, with notable differences between the wet and dry seasons. Camels belonging to control group of samples were nourished with alfalfa pellets, wheat bran, barley (Hordeum vulgare), corn (Zea mays), olive waste, straw, Medicago sativa, and dry bread (Fig. S1). A detailed summary of all the data related to the dromedaries included in the study were provided in the Supplementary materials (Table S1). Exclusion criteriaAnimals showing clinical concerns, such as illness, injury, or behavioral indications of stress were not included. Camels receiving treatment, recovering from health issues, or recently exposed to transport or intensive handling were likewise omitted. Camels for whom age, physiological condition, or feeding history could not be reliably established were also excluded from the study. Collection and preparation of CU samplesMidstream urine samples were collected in the early morning from selected camels (see subsection 2.2.4: Characteristics of selected camels), following traditional criteria reported by informants namely, animal age, physiological status, pregnancy stage, and dietary regimen. Although the collection process was non-invasive, all procedures were performed under veterinary supervision, in accordance with institutional ethical guidelines to ensure animal welfare. The camels were domesticated animals raised under extensive desert grazing conditions, as previously described in subsection 2.2.5: Collection and preparation of CU samples. Sampling took place on privately owned land, with full permission obtained from the camel owners. The animals were familiar with human interaction and handled exclusively by/experienced attendants during spontaneous urination. No restraint or invasive manipulation was used, ensuring minimal disturbance and maintaining the animals in a stress-free state (see subsection 2.2.5). A total of 62 samples were obtained using a stratified sampling approach to reflect key ethnopharmacological variables believed to influence urine efficacy. Samples were collected hygienically by trained handlers using sterile containers, then promptly placed in ice-packed transport boxes for transfer to the laboratory. Upon arrival, each 200 ml urine sample was divided into two equal portions. The first 100 ml was filtered using Whatman No.1 cellulose acetate filter paper (22 µm pore size) to remove particulates and was designated as non-treated CU (F). The remaining 100 ml was sterilized by autoclaving at 121°C for 20 minutes under 0.1 MPa pressure, forming the treated CU fraction (S). To evaluate the impact of storage on bioactivity, both S and F samples were allocated into two temperature conditions. One group was stored at −20°C, the other at 4°C. Within each group, samples were subdivided for evaluation after 2, 4, and 6 months. These storage parameters were selected based on previous studies demonstrating the stability of urinary bioactive constituents under freezing and refrigeration, aiming to preserve the chemical integrity of the samples throughout the experimental period. Microscopic, and biochemical characterization of CU SamplesMicroscopic analysis was performed using the Sysmex UF-5000® automated urine analyzer (Sysmex Corporation, Kobe, Japan), which operates based on fluorescence flow cytometry to quantify urinary elements such as red blood cells (RBCs), white blood cells (WBCs), epithelial cells, casts, crystals, small round cells, and yeast-like organisms (Wang et al., 2023). For biochemical screening, two complementary approaches were employed. First, a semi-quantitative dipstick test was conducted using Combur-Test® strips (Roche Diagnostics, Mannheim, Germany), which detect parameters such as pH, protein, glucose, and ketones via enzymatic colorimetric reactions (Smyroglou et al., 2023). Second, quantitative biochemical measurements were carried out using the BA400® clinical chemistry analyzer (BioSystems S.A., Barcelona, Spain), a fully automated photometric system used to determine concentrations of urea, creatinine, calcium, uric acid, total protein, and microalbumin. Electrolyte levels, including sodium (Na⁺), potassium (K⁺), and chloride (Cl⁻), were determined with the i-Smart 30 PRO® electrolyte analyzer (i-SENS Inc., Seoul, South Korea), which functions based on ion-selective electrode technology. The analytical procedure was adapted from the protocol reported by Elkhair (2019), with slight modifications. Urinary salinity was measured using the VWR Phenomenal® Multi-Parameter Meter MD 8000 L equipped with the IDP 721-LS conductivity probe (VWR International, Radnor, PA), based on the principle of electrical conductivity. Antibacterial activityMicrobial strains and growth conditionsTwo categories of bacterial strains were used to evaluate the antibacterial activity of CU: reference strains from international collections and MDR clinical isolates (Table 1). Table 1. Characteristics of MDR bacterial strains.
The reference strains included Staphylococcus aureus ATCC 29213 (SA 29213), Enterococcus faecalis ATCC 29212 (EF 29212), Escherichia coli ATCC 25922 (EC 25922), and Pseudomonas aeruginosa ATCC 27853 (PA 27853). These strains were used as quality controls for method standardization and comparative evaluation. The MDR clinical isolates consisted of a panel of Gram-positive and Gram-negative bacteria, including one Methicillin-resistant S. aureus (S. aureus 1), one Vancomycin-resistant Enterococcus faecium (E. faecium 1), one Carbapenemase-producing Klebsiella pneumoniae (K. pneumoniae 1), one Multidrug-resistant E. coli (E. coli 1), one P. aeruginosa (P. aeruginosa 1), one Acinetobacter baumannii (A. baumannii 1), one Enterobacter cloacae (E. cloacae 1), and one Klebsiella oxytoca (K. oxytoca 1). These clinical strains were recovered from various biological fluids (cerebrospinal, peritoneal, pleural, ascitic fluids, urine, blood, and pus) of inpatients at the University Hospital Center of Marrakech, Morocco. Each isolate was confirmed and identified using matrix-assisted laser desorption ionization-time of flight mass spectrometry (MALDI-TOF MS) (Bruker Daltonics, Bremen, Germany), and antimicrobial susceptibility profiles were determined using the Phoenix™ Automated Microbiology System (BD Diagnostics, Sparks, MD) (see Table S2 in the supplementary file). To verify the presence of carbapenemase-producing strains, the NG-Test Carba 5® (NG Biotech, Guipry, France) was employed. This immunochromatographic assay enables the rapid identification of the five main carbapenemase families: KPC, OXA-48-like, NDM, VIM, and IMP. All strains were subcultured on freshly prepared Mueller-Hinton Agar (MHA; Oxoid, UK) and incubated at 37°C for 18–24 hours. Bacterial suspensions were prepared in sterile saline and adjusted to 0.5 McFarland turbidity (equivalent to ~5 × 105 CFU/ml) using the PhoenixSpec™ nephelometer (BD Diagnostics, USA). Prior to each assay, purity and viability of the inocula were confirmed by colony morphology and Gram staining. Agar well diffusion methodThe antibacterial activity of CU samples was assessed using the agar well diffusion method, with minor modifications from the protocol described by Magaldi et al. (2004). All assays were conducted in triplicate to ensure reproducibility and statistical reliability. MHA plates were prepared by pouring 25 ml of medium into sterile 90 mm Petri dishes and allowing them to solidify at room temperature. Once solidified, bacterial suspensions standardized to 0.5 McFarland were evenly spread across the surface using sterile cotton swabs. Sterile cork borers (6 mm diameter) were used to punch uniform wells in the agar. Each well was then filled with 100 µl of undiluted CU (100%, v/v) corresponding to the tested samples (S or F urine samples). Plates were first incubated at ambient temperature for 2 hours to allow pre-diffusion of active compounds, followed by incubation at 37°C for 18–24 hours under aerobic conditions. To validate the experimental conditions, ciprofloxacin (5 µg/disc) served as a positive control, and sterile distilled water was used as a negative control on each plate. Ciprofloxacin (5 µg/disc) was used solely as a reference control to verify strain responsiveness and the consistency of the assay; it was not employed for quantitative comparison with the inhibition zones produced in the agar well diffusion method. The diameters of inhibition zones were measured in millimeters using a calibrated ruler. Only clear, defined zones were considered positive for antibacterial activity. Fourier transform infrared (FTIR) spectroscopy of CUFTIR spectroscopy was employed to analyze the chemical composition of CU samples using attenuated total reflectance (ATR) mode. Measurements were performed with a Jasco FT/IR-4600 spectrometer (Jasco Inc., Tokyo, Japan), operating in the 400–4,000 cm⁻¹ spectral range, with 16 scans per sample and a spectral resolution of 4 cm⁻¹. The sample spectrum was recorded after placing a drop of CU on the diamond ATR crystal. The FTIR technique detects molecular vibrations by measuring the absorbance of infrared radiation at specific wavelengths. The resulting spectra were used to identify characteristic functional groups and assess biochemical variations among the different CU profiles (Sarigul et al., 2023). Statistical analysisAll statistical analyses were performed using IBM SPSS Statistics version 20 (IBM Corp., Armonk, NY). Data from the ethnopharmacological survey were entered and processed in Microsoft Excel prior to import into SPSS. Descriptive statistics, including means, standard SD, frequencies, and percentages, were used to summarize the socio-demographic characteristics of informants and usage patterns of CU. To evaluate the antibacterial activity of CU samples, statistical analyses were conducted using a strain-specific and non-parametric approach. Comparisons between S and F urine samples, as well as between ATCC and MDR isolates, were performed using the Mann–Whitney U test (Obroh et al., 2021). The effect of camel age was assessed separately for each strain across the three age groups (2–5, 6–10, and 11–18 years) using the Kruskal–Wallis test (Kshirsagar et al., 2018). Statistical significance was defined as p < 0.05. Ciprofloxacin was used solely as a quality control standard and was not included in statistical comparisons. A multiple linear regression model was applied to evaluate the combined effects of camel-related variables (physiological status, feeding type, and other relevant factors) on antibacterial activity, expressed as inhibition zone diameter. Before conducting parametric tests, data were examined for normal distribution using the Shapiro-Wilk test, and homogeneity of variances using Levene’s test (Alkhoury et al., 2021). These checks ensured the appropriateness of the statistical models used. All tests were two-tailed, and significance was accepted at p < 0.05. The following thresholds were applied to interpret levels of statistical significance: p < 0.05: significant, p < 0.01: very significant, and p < 0.001: highly significant. To explore potential associations between biochemical parameters (total proteins, urea, creatinine, salinity) and antibacterial activity (measured as zone of inhibition), a Pearson correlation analysis was conducted. Only correlations with p < 0.05 were considered statistically meaningful. A multivariate multiple regression (MMR) analysis was performed to evaluate the combined influence of biochemical, microscopic, physiological, dietary, seasonal, and treatment-related factors on CU antibacterial activity. Ten inhibition-zone measurements from ATCC and MDR strains were analyzed simultaneously as multivariate outcomes. All computations were conducted in Python (version 3.10.12), and the resulting standardized coefficients were visualized as a heatmap. In addition, a multiple linear regression model was applied to assess the combined influence of camel-related factors (age, breed, physiological status, feeding practices) on the antibacterial effectiveness of urine samples. Zone diameter against selected bacterial strains was used as the dependent variable. The model’s explanatory power (R²) and the significance of individual predictors were reported to identify key drivers of bioactivity. Ethical considerationEthical approval for this study was obtained from the Internal Ethics Committee of the Biology Department, Polydisciplinary Faculty of Beni Mellal, Sultan Moulay Slimane University (Approval No. 1/2022). This authorization covered the ethnopharmacological survey and all procedures involving human participants. Data collection complied with Moroccan legal and constitutional frameworks, including Article 24 of the Moroccan Constitution and Dahir No. 1–09–15 of 22 Safar 1430 (February 18, 2009). Informed, voluntary, and signed consent was obtained from all participants, and confidentiality was ensured by excluding any personally identifiable information. No data that could reveal patient identity were obtained or accessed. The clinical bacterial isolates used in the laboratory assays originated from routine hospital diagnostic procedures and were fully anonymized prior to their transfer to the research team. Their use is covered by the Internal Ethics Committee authorization (Approval No. 1/2022), which extends to all microbiological analyses conducted within the framework of this project. Regarding the animal-related components of the study, CU sampling was conducted non-invasively and without any procedures capable of causing pain, distress, or harm to the animals. All sampling activities were supervised by a licensed veterinarian and performed in accordance with institutional animal welfare guidelines. These activities were conducted under the institutional animal ethics authorization obtained prior to fieldwork (Approval No. USMS-FP-02-11/2024). As the collection of midstream urine involved no restraint, no manipulation, and no interference beyond routine handling during spontaneous urination, Institutional Animal Care and Use Committee approval was not required. No anesthesia, euthanasia, or animal sacrifice was performed. ResultsEthnopharmacological surveyDemographic and social attributes of the study participantsThis investigation involved 230 females (55.11%) and 220 males (48.89%) as participants. The majority of informants (about 55.78%) were between 40 and 60 years of age, followed by 33.33% of respondents (n=150) that were aged between 20 and 40 years, whereas those over 60 years represented 49 individuals (10.89%). Regarding the marital status, there were 277 (61.56%) married interviewees, followed by 125 (27.78%) divorced people, and 48 (10.67%) single ones. In terms of schooling degree, those who completed their tertiary and university education represented the largest proportion (n=199, 44.22%) and (n=141, 31.33%) respectively. There is a notable reduction in percentage among illiterate participants (n=64, 14.22%), followed by those with basic schooling (n=46, 10.22%). Table 2 presents the distribution of the surveyed populations. Table 2. Distribution of CU use by demographic variables, source of knowledge, and perceived efficacy.
Traditional and clinical uses of CUCU use was reported by 80% of participants, with no gender-based difference (p > 0.05). Consumption was most frequent among individuals aged 40–60 years, those who were married, and respondents with secondary schooling and higher income levels. These demographic characteristics showed strong statistical correlations with CU use (p < 0.001). Most users described CU as an effective remedy for infections, and its use was largely transmitted through family practices rather than through healer-based instruction. All information concerning CU use and demographic variables is summarized in Table 2. Types of infectious illnesses traditionally treated using CULocal communities employed CU to treat viral infections, accounting for 187 (52%), namely those affecting the hepatic system (47.22%), and 4.72% for common cold and flu. Of participants, 30% consumed it as a substitute for conventional antibiotics in treating bacterial infections such as tuberculosis (15.56%), stomach ulcer (n=31, 11.92%), tooth and gum infections (n=30, 8.33%), and urinary tract infections (n=13, 3.61%). In case of skin and nail infections, 12.5% of interviewees applied it topically as a dermal formulation. The most prevalent infectious ailments treated with CU are shown in Figure 3.
Fig. 3. Infectious diseases most commonly treated with CU. Properties, preparation, dosage, and administration of CUThe traditional use of CU involved specific knowledge of its features, preparation methods, dosage, and routes of administration, which contributed substantially to its healing properties. A comprehensive scientific investigation was conducted by accounting for all variables potentially affecting efficacy, including breed, physiological status, age, season, gestation, and feeding. Used CU was usually collected from pregnant female camels (n=310, 86.11%), while only 13.89% of respondents preferred to consume the one obtained from virgin camels. The physiological condition of the animal significantly influences the attributed properties of its urine, reflecting its deep roots in local cultural practices. Additionally, they highlighted the importance of its collection from primiparous pregnant camels, with 40% favoring the first trimester, 11.94% prioritizing the 3rd trimester, and the absence of correlation between gestation stage and urine characteristics was noted by (n=144, 46.45%). They underlined as well the medicinal qualities of urine, particularly sampled from camels grazing on spiny plants, thorny shrubs, and vegetation typical of arid environments (99.44%). The influence of seasonal changes on urine quality, namely the wet season, was stated by 45.83%, and 10.83% insisted on collecting it within the dry period. In contrast, 43.33% did not regard the season as a significant determinant. Most of the users showed limited awareness of breed factor (n=248, 68.89%). Nevertheless, 12.22% reported that consumed CU was sourced from both Guerzni and Marmouri breeds, while only 6.67% from Khouari population. Moreover, (n=340, 94.44%) informants found that the age of the camel had no impact on therapeutic attributes of its urine. However, 2.50% used the one originated from animals aged between 3 and 10 years. Likewise, a large proportion (n=276, 76.67%) of participants recorded an absence of link between the color indicator and urine excretion, with just 23.33% opting for the yellow color. In the ongoing survey, the remedy preparation was developed from raw, fresh, and recently collected CU (73.33%) or a mixture of CU and fresh camel milk (26.67%). The storage factor was very essential in shaping urine's efficacy. Most of local inhabitants prioritized its preservation (n=312, 88.67%) with 265 of them kept it in the freezer especially for more than 20 days (n=259, 83.01%) and only 47 who chose the fridge (4°C) as a cold storage unit for less than on week (16.03%). Among the reported routes of administration, oral use was the most common (n=296, 82.22%), followed by topical use (n=64, 17.78%); the urine was wrapped directly in a cloth and applied to the skin areas or it was applied by hand on infected areas. Indigenous inhabitants employed two units of measure including teaspoons from 2 (19.44%) to 3 (13.06%) in case of affected sites or tooth and gum infections as a mouthwash. The teacup was the predominant unit for dosage estimation for the remained viral, fungal and bacterial infections (n=243, 67.50%). Furthermore, morning consumption of CU on an empty stomach was identified as the most preferred practice, reported by 339 individuals (94.17%). Nonetheless, the remedy was taken two hours after food by 3.33% of participants (n=12), whereas only 9 (2.50%) advocated for its use prior to sleeping. The findings revealed that CU intake was discontinued by 44.44% of participants following the onset of recovery, 37.50% of them (n=135) stopped its consumption after 20 days, and just 18.06% after 2 months. For the frequency of administration, 338 of interviewees (93.89%) used CU once daily, two times per day (5.56%) for 4 days (40.28%) or three times per day (0.56%) once per week (42.50%) (Fig. 4).
Fig. 4. Quantitative distribution of CU properties, preparation techniques, dosage strategies, and administration routes. Data analysisWithin the framework of this study, two different forms of CU were utilized, including urine obtained from pregnant female camels and that from virgin camels. Quantitative value indices were applied to analyze the data collected via descriptive statistical techniques (Table 3). Table 3. Quantitative indices of CU used for treating infectious diseases.
RFCBy authenticating the frequency of citation, the most popular category used in the Laayoune Sakia El Hamra and Guelmim Oued Noun regions which is widely accepted among participants is the CU from pregnant camels showing a highest RFC value of 0.68, whereas the least cited, with an RFC of 0.11 for the one originated from virgin camels. FLThe use of FL facilitates the determination of the most cited disease categories addressed by respondents. Findings from this study showed that these index values varied between 2.0% and 50%. The highest FL was determined by the excretion from virgin camels for viral infections, namely hepatitis, followed by the urine from pregnant camels for the same ailment (46.77%), and the lowest FL was indicated by the one isolated from virgin female camels for common cold and flu. ICFThis research employed ICF to determine the consistency of responses regarding the use of urine for specific diseases, indicating that commonly recognized urine categories are favored by many within local communities for their authenticity and longstanding association with ailment management. A high level of consensus among local inhabitants (ICF=1) was exhibited regarding the curing of stomach ulcers due to Helicobacter pylori and tooth and gum infections as well. This was followed by hepatic system viral infections, tuberculosis, and skin rash and nail fungus, all of which exhibited an ICF values of 0.99, 0.98, and 0.96, respectively. The lowest ICF (0.91) was recorded for urinary tract infections, as illustrated in Table 3. CIConcerning treated infectious diseases, the biofluid from pregnant and virgin female camels consumed for hepatitis were both marked by a strong CI of 0.377, followed by healing tuberculosis using the urine from pregnant camel (CI: 0.097). It was also demonstrated that stomach ulcers (CI: 0.068) and tooth bacterial infections (CI: 0.066) were solely treated by gestational CU. A low CI of 0.001 was linked to urine from virgin camels used for urinary tract infections. IARThe first highest IAR was registered for common cold and flu (1.00) with only one variety of excretion collected from virgin camels. With the same category of CU, urinary tract infections had the second highest IAR accounting for 0.987, followed by both bacterial skin infections and skin rash and nail fungus (0.979), then it was succeeded in descending order by the urine from pregnant camels for urinary tract infections (IAR=0.977). The last IAR was recorded for the one gathered from virgins for hepatitis (IAR=0.510). The measurement of agreement among respondents indicated how consistently community members selected a particular type of CU. This highlights the level to which local beliefs and choices align, potentially facilitating easier adoption of long-term CU utilization strategies within the community. Minor side effects following administrationFew side effects were recorded by only 40 of the indigenous informants, and 320 (88.89%) reported the non-association of CU with any evident adverse effects. These undesired outcomes included constipation (15 cases, 37.50 %), diarrhea (11 cases, 27.50 %), dry mouth (8 cases, 20%), dizziness (3 cases, 7.50%), drowsiness (2 cases, 5%), and headache (1 case, 2.5%) (Fig. 5). A significant number of respondents said that these effects appeared following the intake of fresh urine (65%) isolated from breeding female camels (52.50%) by drinking one teacup (55%) in the morning (42.5%) or during a meal (32.50%). Such minor effects are frequently ignored by the community until they naturally resolve. No modifications in dosage or frequency are made, as informants indicated that such effects persist for just two hours (70%) or five hours (30%).
Fig. 5. Distribution of mild adverse reactions reported by informants. Multifactorial evaluation of CU’s antibacterial activity: influence of physiological, environmental, microscopic, storage parameters, and biochemical factorsInfluence of age, breed, and physiological statusesA total of 62 camel-derived urine samples were categorized based on the animals’ age into three distinct groups: 2–5 years, 6–10 years, and 11–18 years. The inhibition zone diameters were significantly influenced by both camel age and urine treatment. Inhibition zone diameters differed significantly among camel age groups (Kruskal–Wallis test, p < 0.001). Overall, camels aged 2–5 years exhibited the lowest inhibition zones, intermediate values were observed in the 6–10 year group, and the highest inhibition zones were consistently recorded in camels aged 11–18 years across most tested strains and for both S and F urine samples, whereas no significant difference was observed between the 2–5 and 11–18 year groups (p=0.951). Significant differences in inhibition zone diameters were observed in a strain-dependent manner between the S and F samples. S urine exhibited significantly higher antibacterial activity (p < 0.001) against EC 25922 and PA 27853. Among MDR strains, significant increases (p < 0.05) in inhibition zones were also recorded for E. coli 1, P. aeruginosa 1, A. baumannii 1, K. oxytoca 1 and E. cloacae 1. In contrast, no significant differences were detected between S and F urine for the remaining strains (Fig. 6A). Regarding the bacterial resistance profile, no overall significant effect was detected when comparing ATCC and MDR strains as grouped categories. However, a clear strain-specific difference was observed for S. aureus, where the SA 29213 strain exhibited significantly larger inhibition zones than its MDR counterpart (S. aureus 1) under both F and S urine conditions (p < 0.001), indicating reduced susceptibility of the MDR isolate.
Fig. 6. Comparative antibacterial activity of CU based on camel age, breed, and status. SA 29213: Staphylococcus aureus ATCC 29213/ EF 29212: E. faecalis ATCC 29212, EC 25922: Escherichia coli ATCC 25922/ PA 27853: Pseudomonas aeruginosa ATCC 27853/ S. aureus 1: Methicillin-resistant Staphylococcus aureus, E. faecium 1: Vancomycin-resistant Enterococcus faecium/ K. pneumoniae 1: Carbapenemase-producing Klebsiella pneumoniae/ E. coli 1: Carbapenemase-producing Escherichia coli/ P. aeruginosa 1: Carbapenemase-producing Pseudomonas aeruginosa/ A. baumannii 1: Carbapenemase-producing Acinetobacter baumannii/ E. cloacae 1: Carbapenemase-producing Enterobacter cloacae/ and K. oxytoca 1: Carbapenemase-producing Klebsiella oxytoca; Statistical significance is represented by asterisks: *p < 0.05, **p < 0.001, ***p < 0.0001. No consistent breed-dependent effect on antibacterial activity was observed across all tested strains. When comparing S and F urine samples within each breed, S samples tended to produce larger inhibition zones than F samples; however, these differences were not statistically significant for Guerzni (p=0.058), Khouari (p=0.124), or Marmouri (p=0.097). In contrast, strain-matched comparisons between ATCC and MDR strains of S. aureus revealed significant differences in Khouari and Marmouri camels, with the MDR strain exhibiting significantly lower inhibition zones than the ATCC reference strain (Khouari: p=0.033; Marmouri: p=0.0058), whereas no significant difference was observed in Guerzni camels (p=0.599). No significant ATCC–MDR differences were detected across any breed for the remaining strains (p > 0.05) (Fig. 6B). Differences in CU bioactivity according to physiological conditions and pregnancy duration are illustrated in Figure 6C. Antibacterial activity was assessed in samples from virgin camels and those in successive stages of pregnancy (first to third trimester), with S and F samples compared across both bacterial strain types. S urine generally exhibited higher mean inhibition zones than F samples; however, these differences did not reach statistical significance within individual status categories. Among pregnant camels, inhibition zone diameters increased with gestational progression, reaching maximal values during the second trimester (Kruskal–Wallis test, p < 0.001). No significant differences were observed between virgin camels and the first or third trimester, nor between the first and third trimesters of pregnancy. To further investigate the combined influence of camel-related variables on CU activity, a multiple linear regression model was applied. Physiological status and feeding type were significant predictors of antibacterial activity in the regression model (R²=0.41, p < 0.01). When all samples were analyzed collectively, S urine exhibited significantly higher antibacterial activity than F urine (mean inhibition zone diameter: 13.5 vs. 11.7 mm; Mann–Whitney U test, p < 0.01). This global comparison indicates an overall enhancement of antibacterial activity following treatment; however, stratified analyses showed that the magnitude and significance of this effect varied according to camel-related factor. In contrast, no inhibition zones were detected for EF 29212 and E. faecium 1 across any age group, breed, or physiological status indicating an absence of detectable antibacterial activity against these strains. Ciprofloxacin, used as a quality control standard, showed minimal inhibitory activity against all MDR bacterial strains, confirming their resistance profile. In contrast, both S and F CU samples produced significantly larger inhibition zones (p < 0.01), as determined using the Mann–Whitney U test. CU inhibited the growth of multiple MDR strains, indicating that it may hold value for addressing resistant infections (Fig. 7).
Fig. 7. Agar well diffusion assay showing antibacterial activity of undiluted CU (100 µl per well) against the tested bacterial strains. A, B, C, D, E, and F correspond to CU samples. PV1: Pseudomonas aeruginosa producing Verona integron-encoded metallo-beta-lactamase. EN1: Escherichia coli producing New Delhi metallo-beta-lactamase (NDM). EC1: Enterobacter cloacae with NDM. KPO1: Klebsiella pneumoniae co-producing OXA-48, NDM, and extended-spectrum beta-lactamase. Influence of seasonal and dietary factorsFigure 8A shows an assessment of inhibition zone differences as influenced by season, which are represented by wet and dry periods. Overall, S samples tended to show higher antibacterial activity than F urine, but this effect was not statistically significant in strain-specific analyses (p > 0.05). Likewise, no significant differences were observed between ATCC strains and their MDR counterparts across seasons (p > 0.05). Seasonal variation did not significantly influence antibacterial activity, as inhibition zones did not differ between dry and wet seasons for any strain. Collectively, these findings indicate that neither season nor resistance status significantly modulates antibacterial activity at the strain level (Fig. 8A).
Fig. 8. Seasonal and nutritional influences on CU antibacterial efficacy. SA 29213: Staphylococcus aureus ATCC 29213/ EF 29212: E. faecalis ATCC 29212, EC 25922: Escherichia coli ATCC 25922/ PA 27853: Pseudomonas aeruginosa ATCC 27853/ S. aureus 1: Methicillin-resistant Staphylococcus aureus, E. faecium 1: Vancomycin-resistant Enterococcus faecium/ K. pneumoniae 1: Carbapenemase-producing Klebsiella pneumoniae/ E. coli 1: Carbapenemase-producing Escherichia coli/ P. aeruginosa 1: Carbapenemase-producing Pseudomonas aeruginosa/ A. baumannii 1: Carbapenemase-producing Acinetobacter baumannii/ E. cloacae 1: Carbapenemase-producing Enterobacter cloacae/ and K. oxytoca 1: Carbapenemase-producing Klebsiella oxytoca; Statistical significance is represented by asterisks: *p < 0.05, **p < 0.001, ***p < 0.0001; Feed A, B, C, D, E, F [See details in the Supplementary materials (Table S1)]. The influence of animal feed on the antibacterial activity of CU was evaluated using a strain-specific approach across feeds A, B, C–E, and F, taking into account both treatment condition (S vs. F) and strain type (ATCC vs. MDR). The results indicated that feeding type modulated antibacterial activity in a strain-dependent manner. In feed A, S urine showed significantly higher inhibition zones than F urine for EC 25922 (p=0.0497) and K. oxytoca 1 (p=0.0409), whereas in feed B, a marked treatment effect was observed for A. baumannii 1 (p=0.0010) and E. cloacae 1 (p=0.0166). In contrast, no significant treatment-associated differences were detected in the C, D and E feeds or in feed F for any strain (p > 0.05). Comparisons between ATCC and their corresponding MDR isolates revealed no statistically significant differences across any feeding category (p > 0.05 for all matched pairs). Notably, feeds C–D–E showed no detectable antibacterial activity against any tested strain. Collectively, these findings indicate that feeding type influences the magnitude of antibacterial activity in a strain-specific manner, with treatment effects evident for selected strains under specific feeding conditions. Figure 8B depicts the impact of distinct feeding regimens on antibacterial activity, as reflected by inhibition zone measurements. Effect of storage time and temperatureBased on indigenous practices, participants specifically recommended two storage conditions: refrigeration at 4°C and freezing at −20°C. At 4°C, a significant reduction in inhibition zone diameters was observed with increasing storage time for several bacterial strains, indicating a progressive loss of antibacterial activity. This effect was strain dependent and more pronounced in F samples. Kruskal–Wallis analysis revealed a significant influence of storage duration for A. baumannii 1 and E. cloacae 1 (p < 0.0001), with pairwise comparisons showing markedly lower inhibition zones at 6 months compared with 2 months (p < 0.01). Similar trends were observed for K. pneumoniae 1 and K. oxytoca 1, where inhibition zones decreased significantly between early and prolonged storage. In contrast, S samples generally exhibited higher mean inhibition zones than F ones, although statistically significant differences between S and F urine were detected only for A. baumannii 1 after 2 months of storage (p=0.0417). Strain-matched comparisons further revealed that SA 29213 consistently displayed significantly larger inhibition zones than its MDR counterpart across all storage times (p=0.0016), whereas no significant ATCC–MDR differences were observed for other strains (p > 0.05). Overall, these results demonstrate that storage at 4°C leads to a time-dependent decline in antibacterial activity, particularly affecting specific strains and F samples (Fig. 9A).
Fig. 9. Effect of storage duration and temperature on CU antibacterial activity. SA 29213: Staphylococcus aureus ATCC 29213/ EF 29212: E. faecalis ATCC 29212, EC 25922: Escherichia coli ATCC 25922/ PA 27853: Pseudomonas aeruginosa ATCC 27853/ S. aureus 1: Methicillin-resistant Staphylococcus aureus, E. faecium 1: Vancomycin-resistant Enterococcus faecium/ K. pneumoniae 1: Carbapenemase-producing Klebsiella pneumoniae/ E. coli 1: Carbapenemase-producing Escherichia coli/ P. aeruginosa 1: Carbapenemase-producing Pseudomonas aeruginosa/ A. baumannii 1: Carbapenemase-producing Acinetobacter baumannii/ E. cloacae 1: Carbapenemase-producing Enterobacter cloacae/ and K. oxytoca 1: Carbapenemase-producing Klebsiella oxytoca; Statistical significance is represented by asterisks: *p < 0.05, **p < 0.001, ***p < 0.0001. In contrast to refrigeration, storage at −20°C preserved the antibacterial activity of CU over time. No significant differences in inhibition zone diameters were detected between 2, 4, and 6 months of storage for any strain (Kruskal–Wallis test, p > 0.05 for all comparisons), indicating stable antibacterial efficacy under frozen conditions. Similarly, no statistically significant differences were observed between the S and F samples at any storage duration (p > 0.05), although the S samples consistently showed slightly higher mean inhibition zones. Strain-specific analyses confirmed that the susceptibility pattern between ATCC and MDR isolates remained unchanged during frozen storage; SA 29,213 continued to exhibit significantly higher inhibition zones than the MDR strain at all time points (p=0.0016), while no ATCC–MDR differences were observed for other species (p > 0.05). These findings indicate that freezing at −20°C effectively preserves the antibacterial properties of CU and prevents the storage-related degradation observed under refrigerated conditions (Fig. 9B). Influence of biochemical and microscopic characteristicsTo investigate the relationship between CU composition and its antibacterial activity, Pearson correlation analyses were conducted between inhibition zone diameters and 16 biological variables. These included physicochemical parameters (salinity, pH, Na⁺, K⁺, Cl⁻), biochemical markers (urea, creatinine, uric acid, total proteins, glucose, and ketones), and microscopic elements (WBCs, RBCs, casts, crystals, epithelial cells, and yeasts). Data were stratified by bacterial strain type (ATCC vs. MDR) and urine treatment condition (F vs. S), resulting in four distinct correlation profiles. Spearman correlation analysis revealed significant strain-dependent associations between several biochemical and microscopic parameters and the antibacterial activity of CU. In F samples (Fig. 10A), protein-related parameters were positively correlated with inhibition zones against SA 29213 and its MDR counterpart, indicating that higher protein content was associated with enhanced antibacterial activity (p < 0.05). Similarly, salinity and conductivity parameters were significantly correlated with inhibition zones against EC 25922, suggesting a potential contribution of ionic composition to antibacterial efficacy (p < 0.05).
Fig. 10. Heatmap showing the impact of microscopic and biochemical variables on CU activity. SA 29213: Staphylococcus aureus ATCC 29213/ EF 29212: E. faecalis ATCC 29212, EC 25922: Escherichia coli ATCC 25922/ PA 27853: Pseudomonas aeruginosa ATCC 27853/ S. aureus 1: Methicillin-resistant Staphylococcus aureus, E. faecium 1: Vancomycin-resistant Enterococcus faecium/ K. pneumoniae 1: Carbapenemase-producing Klebsiella pneumoniae/ E. coli 1: Carbapenemase-producing Escherichia coli/ P. aeruginosa 1: Carbapenemase-producing Pseudomonas aeruginosa/ A. baumannii 1: Carbapenemase-producing Acinetobacter baumannii/ E. cloacae 1: Carbapenemase-producing Enterobacter cloacae/ and K. oxytoca 1: Carbapenemase-producing Klebsiella oxytoca; Statistical significance is represented by asterisks: *p < 0.05. EC: epithelial cells; RBC: red blood cells; WBC: white blood cells. In S samples (Fig. 10B), the pattern of correlations was more pronounced and strain-specific. Several biochemical parameters displayed significant positive correlations with antibacterial activity against PA 27853 and K. pneumoniae 1, whereas weaker or non-significant associations were observed for other strains. In contrast, parameters such as glucose and ketone levels did not show statistically significant correlations with inhibition zones across most tested strains in either treatment condition (p > 0.05). Overall, these findings highlight that the relationship between biochemical composition and antibacterial activity of CU is both strain-dependent and influenced by urine treatment. FTIR of both S and F urine samplesIn this study, three of the most effective samples exhibiting the highest antibacterial activity were selected from 62 samples for FTIR analysis, each in S and F forms. The objective of this study was to identify the key functional groups and chemical differences that may account for the superior efficacy of the S samples compared with their F counterparts. The FTIR spectra of S samples: V21, G16, and G19 are displayed in Figure 11A with vertical offsets for clarity. All three spectra exhibited characteristic absorption bands indicative of functional groups commonly found in bioactive compounds. Notable peaks were observed at approximately 3,345 cm⁻¹ (O–H/N–H stretching), 1,362 cm⁻¹ (C–H stretching), 2,133 cm⁻¹ (C=C or C-N stretching of alkynes or nitriles), and 1,050 cm⁻¹ (C–O stretching of alcohols or esters). These bands reflect the presence of amino acids, proteins, urea derivatives, and other nitrogen- and oxygen-containing metabolites.
Fig. 11. FTIR spectra comparison of treated and non-treated CU. Compared to the non-treated group (Fig. 11B), the S samples showed a relative sharpening and intensification of several bands, especially in the fingerprint region (1500–600 cm⁻¹), namely 1388 cm-1, suggesting removal of interfering compounds or enhancement in specific chemical constituents. The V21 sample in particular demonstrated strong and well-defined peaks, implying a higher concentration or better resolution of active components post-treatment. The annotations of peak wavenumbers further substantiate these observations and provide a molecular fingerprint relevant for assessing the functional role of these samples in biological activity assays. Minor transmittance values exceeding 100% observed in Figure 11A and B are attributed to baseline offsets introduced during the automatic background-correction process of the FTIR instrument. This artifact, frequently encountered in aqueous biological samples, does not affect the accuracy of band positions or the reliability of the functional-group assignments. Multivariate regression profile of CU antibacterial performanceThe multivariate multiple regression heatmap (Fig. 12) provides an integrated visualization of how CU antibacterial activity is collectively shaped by biochemical composition, microscopic elements, camel-related attributes, and treatment conditions. The S samples showed the strongest and most consistent positive standardized coefficients across nearly all pathogens, confirming its superior potency when all predictors were simultaneously analyzed. Among the biochemical variables, total proteins, chloride ions, and salinity exhibited the most robust positive associations with inhibition zones, whereas urea, calcium, and uric acid exhibited weaker or negative contributions. Microscopic indicators displayed variable, strain-dependent effects, with crystals acting as a positive determinant for several species, while WBC and epithelial cells were generally weak or negative predictors. Camel-related factors, particularly feeding regimen (notably Feed A) and some physiological categories, also contributed positively but in a pathogen-specific manner. Overall, the multivariate signature demonstrates that CU antibacterial efficacy emerges from the combined influence of treatment, biochemical composition, diet, and selected microscopic features rather than any single dominant factor.
Fig. 12. MMR of predictive variables and antimicrobial activity. SA 29213: Staphylococcus aureus ATCC 29213/ EF 29212: E. faecalis ATCC 29212, EC 25922: Escherichia coli ATCC 25922/ PA 27853: Pseudomonas aeruginosa ATCC 27853/ S. aureus 1: Methicillin-resistant Staphylococcus aureus, E. faecium 1: Vancomycin-resistant Enterococcus faecium/ K. pneumoniae 1: Carbapenemase-producing Klebsiella pneumoniae/ E. coli 1: Carbapenemase-producing Escherichia coli/ P. aeruginosa 1: Carbapenemase-producing Pseudomonas aeruginosa/ A. baumannii 1: Carbapenemase-producing Acinetobacter baumannii/ E. cloacae 1: Carbapenemase-producing Enterobacter cloacae/ and K. oxytoca 1: Carbapenemase-producing Klebsiella oxytoca; Feed B, C, D, E, F [See details in the Supplementary materials (Table S1)]. EC: epithelial cells; RBC: red blood cells; WBC: white blood cells DiscussionThe results of the current survey indicate that CU continues to be commonly employed in traditional medicine by local communities. These ethnographic insights were supported by in vitro antibacterial analyses, which demonstrated that the bioactivity of CU varies in relation to factors such as storage and treatment conditions, seasonal changes, breed, age, physiological statuses, and the dietary regimen of the camels as well as microscopic and physico-biochemical parameters. Ethno-biological influences on antibacterial efficacy of CUIn Moroccan southern regions, Among the 450 participants, 80% reported using CU mainly to treat infectious diseases. This practice was most prevalent among adults aged 40–60 years (n=188), suggesting a decline across generations. Notably, most users were married, highly educated, and earned >5,000 DH/month, indicating that CU consumption is culturally rather than economically driven (Ressmi et al., 2024d). Given that CU is considered a form of alternative and traditional medicine, these findings are consistent with those of Logiel et al. (2021) which exhibited that the usage of traditional medicine by 73% of people was influenced by marital status, education, and income level. Although modern treatments are available, the frequent use of CU for infections and hepatic disorders underscores its relevance as a complementary bioactive resource warranting scientific validation. Hu et al. (2017) demonstrated the capacity of CU to completely protect the stomach lining from ulceration caused by severe stress using in vivo animal models. Additionally, CU consumption for hepatitis treatment also remains common in rural Somalia, reflecting enduring ethnomedical practices (Dogan et al., 2025). Our findings also indicate a high prevalence of CU use for tuberculosis treatment among participants which was aligned with the work of Khorshid (2022)who reported that only 10% of extracted fraction from CU demonstrated a strong antimycobacterial activity. The topical application of CU reported by informants aligns with findings of Elsayed et al. (2024) who highlighted its potential into skincare products, supported by both its ethnomedicinal use and its scientifically observed antibacterial properties. Most respondents preferred urine from female camels, as males are more aggressive during collection, making sample retrieval more difficult and potentially hazardous. The exclusion of male CU was mainly attributed to behavioral difficulties during collection; however, whether such aggression influences urine composition remains unknown and requires further biochemical investigation. (Samimi, 2019). Furthermore, second-trimester pregnant CU was most preferred and showed significantly larger inhibition zones against both ATCC and MDR strains than urine from other pregnancy stages. This stronger antibacterial activity in pregnant CU may result from pregnancy-related hormonal and enzymatic changes influencing the bioactive metabolites (Ibrahim et al., 2017). On the other hand, our ethnopharmacological survey revealed that urine from virgin camels was less frequently employed. This contrasts with evidence showing that this type of CU exhibits notable biological effects, including reported anticancer activity through gene-regulatory pathways (Alhaidar et al., 2011). Correspondingly, the experiments of Elbehiry et al. (2021) showed that virgin CU exhibited superior antibacterial activity, fully inhibiting multidrug-resistant E. coli. In laboratory findings of our study, the observed age-dependent differences suggest that camel maturity may influence the antibacterial potential of urine, as higher inhibition zones were mainly associated with samples from older animals aged 11–18 years. This result aligns with the findings of Ghamdi and Khorshid (2012), who reported that age-related physiological changes may enhance the bioactivity of CU, particularly its anticancer potential. CU contains diverse antimicrobial metabolites, and their levels are known to vary with factors such as age and physiological status (Iglesias Pastrana et al., 2022). Renal function also changes with age, as older camels show structural and functional kidney alterations that affect metabolite clearance (Khafaga et al., 2021). Moreover, endocrine fluctuations, including age- and season-dependent changes in testosterone and cortisol, can influence metabolic turnover and excretion (El-Harairy and Attia, 2010; El-Kon, 2018). Together, our data may indicate a comparatively stable mid-age phase with lower bioactive excretion, while younger and older camels show higher activity (Al-Qarawi et al., 2000; Saeed et al., 2004; Mohamed Elkhair, 2016), consistent with age-driven shifts in blood metabolism that are mirrored in urine through renal filtration (Miller et al., 2019). While their findings indicated that urine from the Magateer breed was more active against cancer cells than that from Majaheem (Ghamdi and Khorshid, 2012), no breed effect was detected in our antibacterial testing. This aligns with local knowledge, wherein urine quality is not breed-dependent. and that seasonal effects are mixed, with 45% of informants favoring the wet season or reporting no influence. However, our in vitro results showed no significant variation in antibacterial activity across seasons, suggesting a mismatch between ethnopharmacological perceptions and laboratory evidence. This preference may simply reflect a better nutritional intake from protein-rich desert shrubs during the wet season (Chimsa et al., 2013). Regarding feeding, the higher activity observed with desert-plant feed (feed A; Table S1) may be linked to specific phytochemicals or nutrients, although metabolomic analyses are needed to confirm this hypothesis (Ressmi et al., 2024b); Al-Awadi and Aljudaibi, 2014; Al-Ghumlas et al., 2023; Abibu et al., 2022). Effect of storage on antibacterial activity of CUAs part of the present work, following indigenous knowledge, most participants reported storing CU in the freezer for over 20 days. This practice was validated by laboratory findings, which demonstrated that the antibacterial activity, as measured by inhibition zones, remained stable over storage periods of 2, 4, and 6 months. This is supported by an in vitro study that confirmed the prolonged storage of CU in the freezer for six months did not alter its bioactivity (Al-Awadi and Aljudaibi, 2014). The methods of usage, administration of CU and the mild side effects were all reported by informants and consistent with those described in a previous study(Ressmi et al., 2024d). Influence of CU treatment on antibacterial activityAlthough most of users preferred the use of raw CU, sterilization was performed prior to antibacterial testing due to public health concerns, particularly the potential transmission of Middle East respiratory syndrome coronavirus MERS-CoV from camel-derived products, as highlighted by Centers for disease control and prevention (CDC, 2024). Indeed, our findings underscore that S samples consistently exhibited greater inhibition zones than F ones. Similar results have been reported by Elbehiry et al. (2021) and Humaid (2016) who emphasized the robust antibacterial effect of sterilized CU against many bacterial strains compared to the raw CU. This effect may be associated with to autoclaving-induced physicochemical changes, including reduced salinity and sodium levels (Huber, 2011). These results agree with reports that mild salt stress allows bacterial adaptation and increased tolerance (Yang et al., 2023). Conversely, some studies show that heat-induced membrane disruption releases intracellular ions, especially K⁺ and Cl⁻; a similar mechanism likely applies to bacterial lysis during autoclaving (Ruifrok et al., 1985; Demidchik et al., 2014). Besides, this increased antibacterial activity in S urine may result from chemical changes, supported by the new FTIR peak at 1388 cm⁻¹, corresponding to antimicrobial-related groups (C–H bending or carboxylates). Agatonovic-Kustrin et al. (2021) assign 1388 cm⁻¹ to methyl/isopropyl bending in antioxidant compounds. Similarly, in small organic molecules such as metronidazole, a peak around 1387 cm⁻¹ has been attributed to CH₃ bending vibrations (Kumar Trivedi, 2015). In addition, carboxylate groups exhibit symmetric stretching in the 1450–1360 cm⁻¹ range, and thus the observed band could also correspond to a COO⁻ vibration (Kamnev et al., 2021). In particular, Bidlas and Lambert (2008) reported that potassium and chloride have been shown to possess antimicrobial properties. Similarly, the rise in total proteins, urea, and creatinine likely results from heat-induced cellular disruption and protein breakdown during autoclaving (Kurbatov et al., 2023). A comparable outcomes were observed by Mcdonald et al. (2012) and Burt and Dempsey (1977) who affirmed that creatinine prevented bacterial growth and they underscored as well the potential of urea as a supportive agent in antibacterial therapy namely against E. coli and S. aureus respectively. Additionally, the rise in urine pH from 8 to 9 from heat-induced breakdown of nitrogenous compounds may enhance alkalinity and further inhibit bacterial membranes and metabolism (Lin et al., 2021). Collectively, these chemical alterations suggest a multifactorial mode of action by which autoclaving enhances the antibacterial efficacy of CU, similar to other natural extracts where heat sterilization alters antibacterial activity by changing key chemical components (Hashemi et al., 2008). ATCC and MDR bacterial strainsIn light of our strain-specific analyses, CU did not induce a uniform difference in antibacterial activity between ATCC and their corresponding MDR isolates. For most tested species, inhibition zone diameters were comparable between ATCC and MDR strains, indicating that resistance status alone does not systematically influence susceptibility to CU. A notable exception was observed for S. aureus, where SA 29213 consistently exhibited significantly larger inhibition zones than its MDR counterpart across multiple experimental conditions, including storage time, age and breed. While antibacterial resistance is often associated with physiological adaptations such as altered permeability or efflux mechanisms that could theoretically modulate responses to unconventional antibacterial agents (Blair et al., 2015; Zampieri et al., 2017), our paired strain comparisons suggest that such effects are not universal and vary according to bacterial species. Consequently, interpretations regarding differential ATCC–MDR susceptibility should be made with caution until targeted mechanistic studies clarify the underlying determinants of CU activity (Bharadwaj et al., 2022). In the present study, ciprofloxacin discs were included solely as a quality-control/reference standard to verify strain responsiveness and assay consistency; accordingly, inhibition zone diameters obtained using agar well diffusion (cup-plate) with camel urine were not interpreted as directly equivalent to those produced by standard antibiotic discs, given the known differences in diffusion kinetics and test conditions between the two methods (Güven et al., 2005; Aqil et al., 2005; Cheruiyot et al., 2009; Asfa et al., 2025). The lack of an MDR-specific antibiotic control in agar wells remains a methodological limitation that should be addressed in future studies. FTIR analysisFTIR analysis of the most potent CU samples (V21, G16, and G19) revealed distinct spectral differences between S and F forms, suggesting compositional changes that may contribute to enhanced antibacterial activity. These findings highlight the potential influence of chemical modification on CU bioactivity; however, FTIR provides only qualitative evidence and cannot establish direct causality. Further studies involving a larger number of samples and statistical correlations between spectral features and inhibition zones are required to confirm these associations. Among these, sulfur-based heterocycles were the most dominant group, which are well-documented in pharmacology for their broad spectrum of biological activities, including antibacterial properties (El-Nadi and Al-Torki, 2007). The absorption bands detected at approximately 1,388 and 1,050 cm⁻¹, although they may coincide with C–O stretching vibrations, can also be attributed to S=O functional groups. This assignment is in line with the antibacterial activity observed in the first-trimester samples, where sulfur-containing metabolites are thought to play a role. Moreover, spectroscopic studies of plant phenolics reported 1,388 cm⁻¹ as characteristic of caffeoylquinic acid derivatives (Zhang et al., 2022). Indeed, the functional groups of amino acids, proteins, phenolic acids, and urea derivatives are recognized for their ability to damage cell membranes, bind essential ions, or impair bacterial metabolism, thereby contributing to antibacterial action (Hasrudin et al., 2020; Dal Poggetto et al., 2021). Multivariate interpretation of CU antibacterial activityThe multivariate analysis showed that CU antibacterial activity results from the combined influence of treatment, biochemical composition, and camel-related factors, in line with evidence that CU bioactivity depends on a complex mixture of metabolites and physicochemical properties (Ressmi et al., 2024b). The strong positive effect of treatment is consistent with reports that processing and preparation conditions can modulate the chemical profile and enhance the biological activity of CU and related biofluids (Ahamad et al., 2017). The prominence of proteins, salinity, and chloride as positive predictors reflects broader findings that ionic strength, mineral content, and nitrogenous compounds shape antimicrobial efficacy in complex matrices (Ferroni Passos and Nitschke, 2024). Finally, the pathogen-specific contribution of microscopic and camel-related variables mirrors the ecological and seasonal variability observed in natural-product antimicrobial systems analysed with multivariate methods (do Nascimento et al., 2019). Together, these findings underscore the value of multivariate approaches for clarifying antimicrobial mechanisms in heterogeneous biological samples such as CU. Ethnopharmacological data collected from local inhabitants serve as a crucial foundation for studying camel-based resources, with a particular focus on CU, to identify bioactive molecules. Our scientific process focused on the in vitro assessment of CU's antibacterial activity against ATCC and MDR bacteria, examining various influencing factors such as camel age, breed, physiological status, feeding practices, and biochemical parameters. Additionally, FTIR analysis was conducted to characterize the chemical composition and further understand the factors impacting bioactivity. Subsequent stages could involve extraction, purification (via LC-MS, GC-MS and NMR), preclinical safety and efficacy testing (in vitro, in vivo, and in silico), clinical trials, and drug formulation. A multidisciplinary strategy integrating ethnopharmacology, microbiology, and analytical chemistry may support the development of evidence-based therapeutic applications from CU, while also contributing to the preservation and scientific validation of traditional practices. ConclusionIn conclusion, this ethnopharmacological investigation confirms the antibacterial potential of CU and identifies key determinants of its bioactivity. Urine from camels aged 11–18 years, particularly in early pregnancy (second trimester), exhibited the greatest inhibitory activity, whereas breed and season had no significant effect, suggesting a broadly consistent antimicrobial profile across lineages and environments. Our findings also show that ATCC–MDR susceptibility differences were species-dependent, reinforcing the selective and organism-specific nature of CU’s antibacterial action. Autoclaving enhanced efficacy by reducing salinity and sodium while increasing pH, ions, and metabolites, a transformation supported by the emergence of a distinct FTIR band at 1388 cm⁻¹, indicative of new functional groups linked to heightened bioactivity. This study not only underscores a promising avenue for drug discovery and therapeutic development but also calls for further pharmacological and mechanistic studies, including the isolation of the active compounds and elucidation of their modes of action to fully harness and translate CU’s bioactive properties into effective clinical applications. Conflict of interestThe authors declare that they have no known competing financial interests or personal relationships that could have influenced the work reported in this paper. FundingThis research did not receive any specific grant from public, commercial, or not-for-profit funding agencies. Author’s contributionsRA and BA conceived and designed the study. RA wrote the manuscript. RH, AR, AD, and YHM participated in data collection and analysis. RA and BA contributed to the results interpretation. SN and BA have approved the final draft of the manuscript. All authors have read and approved the final version of the manuscript to be published. Data availabilityAll data supporting this study’s findings are available within the manuscript. ReferencesAbdalla, I., Haroun, E. and Abdalla, H. 2018. Effects of type of nutrition on the chemical composition of camels milk and urine. Gezira. J. Agric. Sci. 16. Abdel Gader, A.G.M. and Alhaider, A.A. 2016. The unique medicinal properties of camel products: a review of the scientific evidence. J. Taibah. Univ. Med. Sci. 11, 98–103; doi:10.1016/j.jtumed.2015.12.007 Abibu, W., Javed, A., Janay , A., 2022. Organoleptic and medicinal properties of camel urine and camel milk. https://doi.org/10.52460/issc.2022.028 Agatonovic-Kustrin, S., Balyklova, K.S., Gegechkori, V. and Morton, D.W. 2021. HPTLC and ATR/FTIR Characterization of antioxidants in different rosemary extracts. Molecules 26, 6064; doi:10.3390/molecules26196064 Ahamad, S.R., Alhaider, A.Q., Raish, M. and Shakeel, F. 2017. Metabolomic and elemental analysis of camel and bovine urine by GC–MS and ICP–MS. Saudi J. Biol. Sci. 24, 23–29; doi:10.1016/j.sjbs.2015.09.001 Al-Abdalall, A.H.A. 2010. The inhibitory effect of camel’s urine on mycotoxins and fungal growth. Afr. J. Agric. Res. 5, 1331–1337; doi:10.5897/AJAR09.686 Al-Ghumlas, A.K., Alhakbany, M.A. and Korish, A.A. 2023. Antiapoptotic and anticoagulant effects of camel milk and camel urine in methotrexate-induced hepatotoxicity. CyTA. -. J. Food 21, 357–365; doi:10.1080/19476337.2023.2202709 Alhaidar, A., Abdel Gader, A.G.M. and Mousa, S.A. 2011. The antiplatelet activity of camel urine. J. Altern. Complement. Med. 17, 803–808; doi:10.1089/acm.2010.0473 Alhaider, A.A., El Gendy, M.A.M., Korashy, H.M. and El-Kadi, A.O.S. 2011. Camel urine inhibits the cytochrome P450 1a1 gene expression through an AhR-dependent mechanism in Hepa 1c1c7 cell line. J. Ethnopharmacol. 133, 184–190; doi:10.1016/j.jep.2010.09.012 Alkhoury, K., Edrees, A., Sodhi, J., Borgaonkar, A., Shekhar, P., 2021. Investigating students’ expectations of instruction in engineering laboratory courses during the COVID-19 pandemic. Paper presented at the 2021 ASEE Virtual Annual Conference Content Access, Virtual Conference. https://doi.org/10.18260/1-2--37400 Al-Qarawi, A.A., Abdel-Rahman, H.A., El-Belely, M.S. and El-Mougy, S.A. 2000. Age-related changes in plasma testosterone concentrations and genital organs content of bulk and trace elements in the male dromedary camel. Anim. Reprod. Sci. 62, 297–307; doi:10.1016/s0378-4320(00)00146-9 Amina, R., Habiba, R. and Abouddihaj, B. 2024. Camel urine as a potential source of bioactive molecules showing their efficacy against pathogens: a systematic review. Saudi. J. Biol. Sci. 31, 103966; doi:10.1016/j.sjbs.2024.103966 Amina, R., Rafik, A., Habiba, R., Asmaa, D. and Abouddihaj, B. 2024. Ethnopharmacological survey of the therapeutic use of camel urine in the Guelmim-Oued Noun and Laayoune-Sakia El Hamra regions of Morocco. Sci. Afr. 26, 2377; doi:10.1016/j.sciaf.2024.e02377 Amsterdam, D. 2024. Confronting accelerating global antimicrobial resistance and the associated increase in deaths. BioMed. 4. 4, 314–317; doi:10.3390/biomed4030025 Aqil, F., Khan, M.S.A., Owais, M. and Ahmad, I. 2005. Effect of certain bioactive plant extracts on clinical isolates of β-lactamase producing methicillin resistant Staphylococcus aureus. J. Basic. Microbiol. 45, 106–114; doi:10.1002/jobm.200410355 Asfa, B., Woldemichael, D.N., Tesfaw, L., Asefa, L., Desta, S., Girma, S., Tolera, T.S. and Tufa, T.B. 2025. Evaluating antimicrobial activity of selected medicinal plant extracts against pasteurellosis-causing bacteria in small ruminants. Front. Vet. Sci. 12, 1563208. doi:10.3389/fvets.2025.1563208 Awatif Aljudaibi, A.A. 2014. Effects of heating and storage on the antifungal activity of camel urine. Clin. Microbiol. Open Access 3, doi: 10.4172/2327-5073.1000179 Bass, N.M. and Williams, R.L. 1988. Guide to drug dosage in hepatic disease. Clin. Pharmacokinet. 15, 396–420; doi:10.2165/00003088-198815060-00004 Bharadwaj, A., Rastogi, A., Pandey, S., Gupta, S. and Sohal, J.S. 2022. Multidrug-resistant bacteria: their mechanism of action and prophylaxis. BioMed Res. Int. 2022, 5419874; doi:10.1155/2022/5419874 Bakhsh RS, Noor SO, Khorshid FA, Alsulaimany FA, Alzahrani A, Najjar AA, et al. The antibacterial activity of a fraction extracted from camel urine against Mycobacterium tuberculosis isolated from tuberculosis patients in Jeddah city. Advances in Environmental Biology. 2019;13(4):1–6. https://doi.org/10.22587/aeb.2019.13.4.1 Bidlas, E. and Lambert, R.J.W. 2008. Comparing the antimicrobial effectiveness of NaCl and KCl with a view to salt/sodium replacement. Int. J. Food. Microbiol. 124, 98–102; doi:10.1016/j.ijfoodmicro.2008.02.031 Blair, J.M., Webber, M.A., Baylay, A.J., Ogbolu, D.O. and Piddock, L.J. 2015. Molecular mechanisms of antibiotic resistance. Nat. Rev. Microbiol. 13, 42–51; doi:10.1038/nrmicro3380 Burt, B.W. and Dempsey, G. 1977. The effect of urea on the activity of some antimicrobial compounds. J. Pharm. Pharmacol. 29, 71P; doi:10.1111/j.2042-7158.197.tb11539.x CDC, 2024. About middle east respiratory syndrome (MERS) [WWW Document]. Middle East Respir. Syndr. MERS. Available via https://www.cdc.gov/mers/about/index.html (Accessed 15 May 2025) Cheruiyot, K.R., Olila, D. and Kateregga, J. 2009. In-vitro antibacterial activity of selected medicinal plants from Longisa region of Bomet district, Kenya. Afr. Health Sci. 9, 42–46. Chimsa, M.B., Mummed, Y., Kurtu, F., Leta, M.U., Hassen, A. and Gemeda, B. 2013. Forage preference of camel calves (Camelus dromedarius) in eastern Ethiopia. J. Anim. Plant. Sci. 23, 1236–1241. Christy, 1996: Christy M.M. Mesa, Arizona, USA: Self-Healing Press; 1994. Your Own Perfect Medicine. Dal Poggetto, G., D’Angelo, A., Blanco, I., Piccolella, S., Leonelli, C. and Catauro, M. 2021. FTIR study, thermal analysis, and evaluation of the antibacterial activity of a MK-geopolymer mortar using glass waste as fine aggregate. Polymers 13, 2970; doi:10.3390/polym13172970 Demidchik, V., Straltsova, D., Medvedev, S.S., Pozhvanov, G.A., Sokolik, A. and Yurin, V. 2014. Stress-induced electrolyte leakage: the role of K+-permeable channels and involvement in programmed cell death and metabolic adjustment. J. Exp. Bot. 65, 1259–1270; doi:10.1093/jxb/eru004 Do Nascimento, T.G., Dos Santos Arruda, R.E., Da Cruz Almeida, E.T., Dos Santos Oliveira, J.M., Basílio-Júnior, I.D., Celerino De Moraes Porto, I.C., Rodrigues Sabino, A., Tonholo, J., Gray, A., Ebel, R.E., Clements, C., Zhang, T. and Watson, D.G. 2019. Comprehensive multivariate correlations between climatic effect, metabolite-profile, antioxidant capacity and antibacterial activity of Brazilian red propolis metabolites during seasonal study. Sci. Rep. 9, 18293; doi:10.1038/s41598-019-54591-3 Dogan, A., Mohamed Ali, A. and Abdullahi Ali, M. 2025. Treatment of complementary and alternative medicine in patients with chronic viral hepatitis from Somalia. Hepat. Mon. 25, doi:10.5812/hepatmon-150636 Elbehiry, A., Marzouk, E., Moussa, I.M., Alenzi, A., Al-Maary, K.S., Mubarak, A.S., Alshammari, H.D., Al-Sarar, D., Alsubki, R.A., Hemeg, H.A., Kabli, S.A. and Attala, O.A. 2021. Multidrug-resistant Escherichia coli in raw milk: molecular characterization and the potential impact of camel’s urine as an antibacterial agent. Saudi. J. Biol. Sci. 28, 2091–2097; doi:10.1016/j.sjbs.2021.01.018 El-Harairy, M.A. and Attia, K.A. 2010. Effect of age, pubertal stage and season on testosterone concentration in male dromedary camel. Saudi J. Biol. Sci. 17, 227–230; doi:10.1016/j.sjbs.2010.04.006 Elkhair, N., 2019. Effect of age on certain urine parameters of young camels (Camelus dromedarius). Online J. Anim. Feed Res. 9, 33–37. El-Kon, B.A.H. 2018. Effect of age and season on the testicular sperm reserve and testosterone profile in camel (camelus dromedarius). Eff. Age Seas. Testic. Sperm Reserve Testosterone Profile Camel 8, 68–72; doi:10.13140/RG.2.1.3627.7921 El-Nadi, A.H. and Al-Torki, A.I. 2007. Chemical and biochemical composition of pregnant camel urine (Camelus dromedarius). Int. J. Biol. Biotechnol. 4, 433–434. Elsayed, M., Ragab, M., El Khoury, J., Kurban, M., Ghoubar, M. and Hassan, N. 2024. Patient awareness, education, and support for atopic dermatitis in Egypt and Lebanon: results of a physician survey and social analytics. Dermatol. Ther. 2024, 5534555; doi:10.1155/2024/5534555 Faye, B., Konuspayeva, G., Nari, A., Koç, A. and Díaz-Medina, E. 2025. The camel milk sector in mediterranean basin. J. Camel Pract. Res. 32(1), 1–8; doi:10.5958/2277-8934.2025.00001.8 Ferroni Passos, T. and Nitschke, M. 2024. The combined effect of pH and NaCl on the susceptibility of Listeria monocytogenes to rhamnolipids. Food. Res. Int. 192, 114744; doi:10.1016/j.foodres.2024.114744 Ghamdi, Z. and Khorshid, F. 2012. Cytotoxicity of the urine of different camel breeds on the proliferation of lung cancer cells, A549. J. Nat. Sci. Res. 2, 9–16. Güven, K., Çelik, S. and Uysal, I. 2005. Antimicrobial activity of Centaurea species. Pharm. Biol. 43, 67–71; doi:10.1080/13880200590903390 Hashemi, S.R., Zulkifli, I., Zunita, Z. and Somchit, M.N. 2008. The effect of selected sterilization methods on antibacterial activity of aqueous extract of herbal plants. J. Biol. Sci. 8, 1072–1076; doi:10.3923/jbs.2008.1072.1076 Hasrudin, A., Abidin, Z., Hiedayati, N. and Prajaputra, V. 2020. Hydrothermal synthesis of multi-color fluorescent carbon dots from sappan Wood (Caesalpinia sappan) as an acid-base indicator. Rev. Chim. 71, 106–112; doi:10.37358/RC.20.8.8285 Hassan, N. 2017. Determination and analysis of informant consensus factor of medicinal plant species used as remedy in Northern Pakistan. J. Biodivers. Environ. Sci. 11, 117–133. HCP Morocco. 2024. Population légale du Royaume du Maroc répartie par régions, provinces et préfectures et communes selon les résultats du recensement général de la population et de l’habitat 2024 [WWW Document]. Site Institutionnel Ht.-commis. Au Plan Roy. Maroc. Available via https://www.hcp.ma/Population-legale-du-Royaume-du-Maroc-repartie-par-regions-provinces-et-prefectures-et-communes-selon-les-resultats-du_a3974.html (Accessed 27 March 2025) Heinrich, M., Ankli, A., Frei Haller, B., Weimann, C. and Sticher, O. 1999. Medicinal plants in Mexico; healers, consensus and cultural importance. Soc. Sci. Med. 47, 1859–1871; doi:10.1016/S0277-9536(98)00181-6 Huber, S.J. 2011. Temperature dependent removal of sodium chloride (NaCl) from synthetic nitrified urine (PhD Thesis). Verlag nicht ermittelbar. https://doi.org/DOI:%252010.5445/IR/1000024783 Humaid, A.A. 2016. Antagonistic effect of camel’s urine on some pathogenic bacterial species. PSM. Vet. Res. 1, 8–12. Hu, Z., Chang, X., Pan, Q., Okechukwu, P and Gu, K. 2017. Gastroprotective and ulcer healing effects of camel milk and urine in HCl/EtOH, non-steroidal anti-inflammatory drugs (Indomethacin), and waterrestraint stress-induced ulcer in rats. Pharmacogn. Mag. 13, 559–565; doi:10.4103/pm.pm_135_17 Ibrahim, M., Abdelrahman, H. and Elmetwaly, H. 2017. Hormonal profile, antioxidant status and some biochemical parameters during pregnancy and periparturient period in dromedary she camel. Egypt. J. Vet. Sci. 48, 81–94; doi:10.21608/ejvs.2017.2040.1022 Iglesias Pastrana, C., Delgado Bermejo, J.V., Sgobba, M.N., Navas González, F.J., Guerra, L., Pinto, D.C.G.A., Gil, A.M., Duarte, I.F., Lentini, G. and Ciani, E. 2022. Camel (Camelus spp.) urine bioactivity and metabolome: a systematic review of knowledge gaps, advances, and directions for future research. Int. J. Mol. Sci. 23, 15024; doi:10.3390/ijms232315024 Kamnev, A.A., Dyatlova, Y.A., Kenzhegulov, O.A., Vladimirova, A.A., Mamchenkova, P.V. and Tugarova, A.V. 2021. Fourier transform infrared (FTIR) spectroscopic analyses of microbiological samples and biogenic selenium nanoparticles of microbial origin: sample preparation effects. Molecules 26, 1146; doi:10.3390/molecules26041146 Khafaga, A.F., Elewa, Y.H.A., Atta, M.S. and Noreldin, A.E. 2021. Aging-related functional and structural changes in renal tissues: lesson from a camel model. Microsc. Microanal. 27, 1–13; doi:10.1017/S1431927621000210 Kshirsagar, M.M., Dodamani, A.S., Karibasappa, G.N., Vishwakarma, P.K., Vathar, J.B., Sonawane, K.R., Jadhav, H.C. and Khobragade, V.R. 2018. Antibacterial activity of garlic extract on cariogenic bacteria: an in vitro study. Ayu 39, 165–168. Kumar Trivedi, M. 2015. Spectroscopic characterization of biofield treated metronidazole and tinidazole. Med. Chem. 5, 340–344; doi:10.4172/2161-0444.1000283 Kurbatov, I., Dolgalev, G., Arzumanian, V., Kiseleva, O. and Poverennaya, E. 2023. The knowns and unknowns in protein–metabolite interactions. Int. J. Mol. Sci. 24, 4155; doi:10.3390/ijms24044155 Lin, Z., Sun, X. and Yang, H. 2021. The role of antibacterial metallic elements in simultaneously improving the corrosion resistance and antibacterial activity of Magnesium alloys. Mater. Des. 198, 109350; doi:10.1016/j.matdes.2020.109350 Logiel, A., Jørs, E., Akugizibwe, P. and Ahnfeldt-Mollerup, P. 2021. Prevalence and socio-economic factors affecting the use of traditional medicine among adults of Katikekile Subcounty, Moroto District, Uganda. Afr. Health. Sci. 21, 1410–1417; doi:10.4314/ahs.v21i3.52 Magaldi, S., Mata-Essayag, S., Hartung De Capriles, C., Perez, C., Colella, M.T., Olaizola, C. and Ontiveros, Y. 2004. Well diffusion for antifungal susceptibility testing. Int. J. Infect. Dis. 8, 39–45; doi:10.1016/j.ijid.2003.03.002 Mcdonald, T., Drescher, K., Weber, A. and Tracy, S. 2012. Creatinine inhibits bacterial replication. J. Antibiot. (Tokyo) 65, 153–156; doi:10.1038/ja.2011.131 Miller, I.J., Peters, S.R., Overmyer, K.A., Paulson, B.R., Westphall, M.S. and Coon, J.J. 2019. Real-time health monitoring through urine metabolomics. Npj. Digit. Med. 2, 109; doi:10.1038/s41746-019-0185-y Mohamed Elkhair, N. 2016. Influence of age and sex on certain serum biochemical parameters of dromedary camels. Nova J. Med. Biol. Sci. 5, 1–8. doi:10.20286/jmbs-050304 Mukasa-Mugerwa, E. 1981. The camel (Camelus dromedarius): a bibliographical review. International Livestock Centre for Africa. ILCA. Available via https://agris.fao.org/agris-search/search.do?recordID=XF8280021 Mustapha, A., Marte, A.M., Makinta, A.A. and Benisheikh, A.A. 2021. Efficacy of camel urine in the management of diabetes mellitus in alloxan induced Albino rats. Int. J. Agric. Sci. Technol. O’hag, and Mohamedani, A.A. 2000. Clinical trials for the treatment of ascites with camel’s urine. J. Arab Board Med. Specializations 2(3), 25–29. Obroh, A.A., Oshim, I.O., Odeyemi, O., Urama, E.U. and Olise, N.A. 2021. Demonstration of the minimum inhibitory concentration (MIC) and minimal bactericidal concentration (MBC) of both Moringa oleifera and Gongronema latifolium extracts mixture against Staphylococcus aureus, Salmonella typhi and Escherichia coli. J. Adv. Med. Pharm. Sci. 23, 46–52; doi:10.9734/jamps/2021/v23i130216 Ruifrok, A.C.C., Kanon, B. and Konings, A.W.T. 1985. Correlation between cellular survival and potassium loss in mouse fibroblasts after hyperthermia alone and after a combined treatment with X rays. Radiat. Res. 101, 326–331; doi:10.2307/3576398 Saeed, A., Hussain, M.M., Khan, I.A., Chand, G. and El-Yousuf, R.A. 2004. Effect of sex and age on blood biochemical profile in camel. J. Camel. Pract. Res. 11, 73–76. Salamt, N., Idrus, R.B.H., Kashim, M.I.A.M. and Mokhtar, M.H. 2021. Anticancer, antiplatelet, gastroprotective and hepatoprotective effects of camel urine: a scoping review. Saudi. Pharm. J. SPJ. 29, 740–750; doi:10.1016/j.jsps.2021.05.006 Samimi, A.S. 2019. Aggressive sexual behavior of a dromedary bull causing sudden death in a male calf-camel. J. Vet. Behav. 31, 1–4; doi:10.1016/j.jveb.2019.01.001 Sarigul, N., Bozatli, L., Kurultak, I. and Korkmaz, F. 2023. Using urine FTIR spectra to screen autism spectrum disorder. Sci. Rep. 13, 19466; doi:10.1038/s41598-023-46507-z Smyroglou, E.D., Athanasiou, L.V., Baka, R.D. and Polizopoulou, Z.S. 2023. Comparative evaluation between visual and automated dipstick urinalyses in dogs. Vet. Sci. 10, 284; doi:10.3390/vetsci10040284 Sumia, A.D., Ali, A. and Majid, M.E. 2016. Antimicrobial activity of camels (Camelus dromedarius) and sheep urine on some pathogenic bacteria. IOSR. J. Agric. Vet. Sci. 09, 65–71; doi:10.9790/2380-0910016571 Tardío, J. and Pardo-de-Santayana, M. 2008. Cultural importance indices: a Comparative analysis based on the useful wild plants of southern Cantabria (Northern Spain). Econ. Bot. 62, 24–39; doi:10.1007/s12231-007-9004-5 Tharwat, M., Almundarij, T., Sadan, M., Khorshid, F. and Swelum, A. 2023. Is camel’s urine friend or enemy? review of its role in human health or diseases. Open Vet. J. 13(10), 1228–1238; doi:10.5455/OVJ.2023.v13.i10.1 Trotter, R. and Logan, M. 2019. Informant consensus: a new approach for identifying potentially effective medicinal plants. pp: 91–112. https://doi.org/10.4324/9781315060385-6 Wang, H., Han, F.F., Wen, J.X., Yan, Z., Han, Y.Q., Hu, Z.D. and Zheng, W.Q. 2023. Accuracy of the sysmex UF-5000 analyzer for urinary tract infection screening and pathogen classification. PLos One 18, 281118; doi:10.1371/journal.pone.0281118 WHO, 2023. Antimicrobial resistance [WWW Document]. Available via https://www.who.int/news-room/fact-sheets/detail/antimicrobial-resistance (Accessed 17 May 2025) Williams, 1994. The Word of Islam. Univ. Tex. Press. Available via https://utpress.utexas.edu/9780292790766/ (Accessed 17 November 2025) Yang, S., Wang, M., Gao, J., Liu, J., Jin, R., Lin, R., Weng, W. and Aweya, J.J. 2023. Sodium chloride augments the antibacterial activity of a novel penaeid shrimp-derived peptide (GPCR10) against halotolerant Staphylococcus aureus. LWT 184, 115096; doi:10.1016/j.lwt.2023.115096 Zampieri, M., Enke, T., Chubukov, V., Ricci, V., Piddock, L. and Sauer, U. 2017. Metabolic constraints on the evolution of antibiotic resistance. Mol. Syst. Biol. 13, 917; doi:10.15252/msb.20167028 Zhang, Y.C., Deng, J., Lin, X.L., Li, Y.M., Sheng, H.X., Xia, B.H. and Lin, L.M. 2022. Use of ATR-FTIR spectroscopy and chemometrics for the variation of active components in different harvesting periods of Lonicera japonica. Int. J. Anal. Chem. 2022, 8850914; doi:10.1155/2022/8850914 Supplementary MaterialTable S1. Overview of the main traits of animals used for urine sample collection.
Table S2. The antimicrobial resistance patterns of the clinical isolates analyzed in this research were evaluated in accordance with the standards set by the Antibiogram Committee of the French Microbiology Society and the European Committee on Antimicrobial Susceptibility Testing (EUCAST). In the results, R represents resistance to a specific antibiotic, S denotes susceptibility, I signify intermediate susceptibility and ‘-’ indicates that the particular antibiotic was not included in the testing panel for the isolate.
Fig. S1. Characteristics of selected camels. | ||
| How to Cite this Article |
| Pubmed Style Ressmi A, Raqraq H, Dihmane A, Aniba R, Mansour YH, Soraa N, Barguigua A. Ethnopharmacological knowledge and antibacterial activity of camel urine in southern Morocco: Influence of physiological, nutritional, and ecological factors. Open Vet. J.. 2026; 16(2): 877-906. doi:10.5455/OVJ.2026.v16.i2.12 Web Style Ressmi A, Raqraq H, Dihmane A, Aniba R, Mansour YH, Soraa N, Barguigua A. Ethnopharmacological knowledge and antibacterial activity of camel urine in southern Morocco: Influence of physiological, nutritional, and ecological factors. https://www.openveterinaryjournal.com/?mno=289040 [Access: June 22, 2026]. doi:10.5455/OVJ.2026.v16.i2.12 AMA (American Medical Association) Style Ressmi A, Raqraq H, Dihmane A, Aniba R, Mansour YH, Soraa N, Barguigua A. Ethnopharmacological knowledge and antibacterial activity of camel urine in southern Morocco: Influence of physiological, nutritional, and ecological factors. Open Vet. J.. 2026; 16(2): 877-906. doi:10.5455/OVJ.2026.v16.i2.12 Vancouver/ICMJE Style Ressmi A, Raqraq H, Dihmane A, Aniba R, Mansour YH, Soraa N, Barguigua A. Ethnopharmacological knowledge and antibacterial activity of camel urine in southern Morocco: Influence of physiological, nutritional, and ecological factors. Open Vet. J.. (2026), [cited June 22, 2026]; 16(2): 877-906. doi:10.5455/OVJ.2026.v16.i2.12 Harvard Style Ressmi, A., Raqraq, . H., Dihmane, . A., Aniba, . R., Mansour, . Y. H., Soraa, . N. & Barguigua, . A. (2026) Ethnopharmacological knowledge and antibacterial activity of camel urine in southern Morocco: Influence of physiological, nutritional, and ecological factors. Open Vet. J., 16 (2), 877-906. doi:10.5455/OVJ.2026.v16.i2.12 Turabian Style Ressmi, Amina, Habiba Raqraq, Asmaa Dihmane, Rafik Aniba, Yosra Hadj Mansour, Nabila Soraa, and Abouddihaj Barguigua. 2026. Ethnopharmacological knowledge and antibacterial activity of camel urine in southern Morocco: Influence of physiological, nutritional, and ecological factors. Open Veterinary Journal, 16 (2), 877-906. doi:10.5455/OVJ.2026.v16.i2.12 Chicago Style Ressmi, Amina, Habiba Raqraq, Asmaa Dihmane, Rafik Aniba, Yosra Hadj Mansour, Nabila Soraa, and Abouddihaj Barguigua. "Ethnopharmacological knowledge and antibacterial activity of camel urine in southern Morocco: Influence of physiological, nutritional, and ecological factors." Open Veterinary Journal 16 (2026), 877-906. doi:10.5455/OVJ.2026.v16.i2.12 MLA (The Modern Language Association) Style Ressmi, Amina, Habiba Raqraq, Asmaa Dihmane, Rafik Aniba, Yosra Hadj Mansour, Nabila Soraa, and Abouddihaj Barguigua. "Ethnopharmacological knowledge and antibacterial activity of camel urine in southern Morocco: Influence of physiological, nutritional, and ecological factors." Open Veterinary Journal 16.2 (2026), 877-906. Print. doi:10.5455/OVJ.2026.v16.i2.12 APA (American Psychological Association) Style Ressmi, A., Raqraq, . H., Dihmane, . A., Aniba, . R., Mansour, . Y. H., Soraa, . N. & Barguigua, . A. (2026) Ethnopharmacological knowledge and antibacterial activity of camel urine in southern Morocco: Influence of physiological, nutritional, and ecological factors. Open Veterinary Journal, 16 (2), 877-906. doi:10.5455/OVJ.2026.v16.i2.12 |